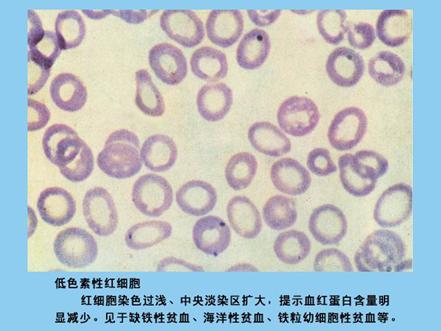

檢驗主管技師輔導:紅細胞染色異常(1)
更新時間:2010-07-01 16:13:35
來源:|0
瀏覽
收藏
檢驗技士/技師/主管技師報名、考試、查分時間 免費短信提醒
檢驗主管技師輔導:紅細胞染色異常(1)
低色素性紅細胞 (hypochromic):
血紅蛋白含量低,中心淺染區擴大。常見于缺鐵性貧血、珠蛋白生成障礙性貧血、鐵粒幼細胞貧血。
更多信息訪問:檢驗主管技師考試頻道 檢驗主管技師考試論壇 醫衛博客圈
編輯推薦
最新資訊
- 2020年檢驗技士/技師/主管技師考試備考壓力大怎么辦?2020-05-11
- 2019年初級檢驗技師考試《微生物學及檢驗》考點解析匯總2018-09-25
- 2019年初級檢驗技師考試《微生物學及檢驗》考點解析:細菌2018-09-25
- 2019年初級檢驗技師考試《微生物學及檢驗》考點解析:微生物特點及分類2018-09-25
- 糖尿病的診斷標準-2019年臨床醫學檢驗技師考試考點輔導資料2018-07-05
- 血清處理方法-2019年臨床醫學檢驗技師考試考點輔導資料2018-07-05
- 干燥綜合征-臨床醫學檢驗技師考試考點輔導2018-06-12
- 細菌的遺傳性狀-臨床醫學檢驗技師考試考點輔導2018-06-10
- 細胞因子受體分類-臨床醫學檢驗技師考試考點輔導2018-06-08
- 精子活動力的分級-臨床醫學檢驗技師考試考點輔導2018-06-08